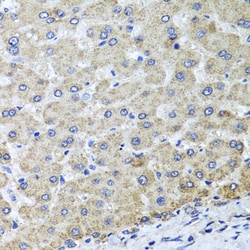
Invitrogen OSGEPL1 Polyclonal Antibody 100 &mu;L; Unconjugated:Antibodies,

Learn More
Invitrogen™ OSGEPL1 Polyclonal Antibody


Rabbit Polyclonal Antibody
Brand: Invitrogen™ PA5117114
Description
Positive Samples: Mouse heart, Mouse kidney, Mouse liver, Mouse testis, Rat liver, Rat brain Immunogen sequence: MLILTKTAGV FFKPSKRKVY EFLRSFNFHP GTLFLHKIVL GIETSCDDTA AAVVDETGNV LGEAIHSQTE VHLKTGGIVP PAAQQLHREN IQRIVQEALS ASGVSPSDLS AIATTIKPGL ALSLGVGLSF SLQLVGQLKK PFIPIHHMEA HALTIRLTNK VEFPFLVLLI SGGHCLLALV QGVSDFLLLG KSLDIAPGDM LDKVARRLSL IKHPECSTMS GGKAIEHLAK QGNRFHFDIK PPLHHAKNCD FSFTGLQHVT DKIIMKKEKE.
OSGEPL1, also known as Qri7, is a 414 amino acid protein that belongs to the KAE1/YgjD family and exists as 3 alternatively spliced isoforms. In tRNAs that have codons beginning with adenine, OSGEPL1 is required for the formation of a threonylcarbamoyl group on adenosine. The gene that encodes OSGEPL1 contains about 16,568 bases and maps to human chromosome 2q32.2. Consisting of 237 million bases, chromosome 2 encodes over 1,400 genes and makes up approximately 8% of the human genome. A number of genetic diseases are linked to genes on chromosome 2. Harlequin icthyosis, a rare and morbid skin deformity, is associated with mutations in the ABCA12 gene. The lipid metabolic disorder sitosterolemia is associated with ABCG5 and ABCG8. An extremely rare recessive genetic disorder, Alstrom syndrome, is due to mutations in the ALMS1 gene.
Specifications
| OSGEPL1 | |
| Polyclonal | |
| Unconjugated | |
| OSGEPL1 | |
| 2610001M19Rik; AA416452; GCP1; HAMAP-Rule:MF_03179}; N6-L-threonylcarbamoyladenine synthase; OSGEPL1; O-sialoglycoprotein endopeptidase like 1; O-sialoglycoprotein endopeptidase-like 1; O-sialoglycoprotein endopeptidase-like protein 1; O-sialoglycoprotein endopeptidase-like protein 1 {ECO:0000255; probable O-sialoglycoprotein endopeptidase 2; probable tRNA N6-adenosine threonylcarbamoyltransferase, mitochondrial; probable tRNA N6-adenosine threonylcarbamoyltransferase, mitochondrial {ECO:0000255; probable tRNA threonylcarbamoyladenosine biosynthesis protein OSGEPL1; putative sialoglycoprotease type 2; Qri7; t(6)A synthase; t(6)A37 threonylcarbamoyladenosine biosynthesis protein OSGEPL1; t(6)A37 threonylcarbamoyladenosine biosynthesis protein Osgepl1 {ECO:0000255; tRNA threonylcarbamoyladenosine biosynthesis protein OSGEPL1; tRNA threonylcarbamoyladenosine biosynthesis protein Osgepl1 {ECO:0000255 | |
| Rabbit | |
| Affinity chromatography | |
| RUO | |
| 314548, 64172, 72085 | |
| -20°C, Avoid Freeze/Thaw Cycles | |
| Liquid |
| ELISA, Immunohistochemistry (Paraffin), Western Blot | |
| 0.88 mg/mL | |
| PBS with 50% glycerol and 0.02% sodium azide; pH 7.3 | |
| Q4V7F3, Q6PEB4, Q9H4B0 | |
| OSGEPL1 | |
| Recombinant fusion protein containing a sequence corresponding to amino acids 1-270 of human OSGEPL1 (NP_0717482). | |
| 100 μL | |
| Primary | |
| Human, Mouse, Rat | |
| Antibody | |
| IgG |
Your input is important to us. Please complete this form to provide feedback related to the content on this product.